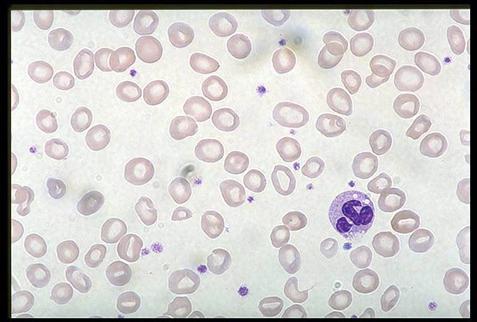

| CATEGORII DOCUMENTE |
| Alimentatie nutritie | Asistenta sociala | Cosmetica frumusete | Logopedie | Retete culinare | Sport |
FIZIOPATOLOGIA ANEMIILOR
Definitie
Anemiile reprezinta o categorie de afectiuni caracterizate prin scaderea concentratiei sanguine a hemoglobinei (Hb) sub 12 g % si a hematocritului (Ht) sub 37%.
Exceptii:
exista posibilitatea aparitiei unei anemii severe, acute, cu Ht si si Hb normale, in conditiile unei hemoragii severe ; hematiile si plasma se pierd rapid, inaintea activarii mecanismelor de compensare prin care organismul incearca sa corecteze volumul plasmatic ; prin urmare, cantitatea de plasma si hematii pierdute sunt echivalente.
exista posibilitatea existentei unei Hb si Ht scazute, fara a fi vorba de anemie, la persoanele hiperhidratate prin terapie intravenoasa.
Mecanisme de compensare
Functia hematiilor este de a transporta oxigenul de la plamani la tesuturi si CO2 de la tesuturi spre plamani. Aceasta este realizata de Hb (proteina tetramerica) formata din HEM si GLOBINA. In anemii este alterata capacitatea de transport a O2 de catre hematii, iar mecanismele de compensare au ca scop ameliorarea transportului de O2 in sange.
Mecanismele de compensare difera, in functie de patogenia si magnitudinea anemiei.
Reglarea volumului plasmatic scazut:
prin mecanisme cardiovasculare - scaderea volumului plasmatic determina hipotensiune arteriala care este detectata de baroreceptorii din bulbul carotidian, arcul aortic, cord, plamani ; stimularea acestora determina generarea de impulsuri nervoase, transmise spre SNC ; consecutiv, este stimulata sinteza de ADH si sistemul nervos vegetative simpatic ; cresterea reabsorbtiei de apa, impreuna cu vasoconstrictia, cresterea rezistentei vasculare periferice si tahicardia, contribuie la refacerea volumului sanguin circulant
prin mecanisme renale - scaderea perfuziei renale stimuleaza sistemul renina-angiotensina-aldosteron ; consecutiv, apare vasoconstrictie si cresterea reabsorbtiei renale de Na+ si apa care corecteaza volumul plasmatic
prin cresterea sintezei hormonilor de contrareglare - hipoxia hipovolemica stimuleaza sinteza de hormoni de contrareglare (glucagon, cortizol si epinefrina) ; consecutiv se produce hiperglicemie → trecerea apei din spatiul intracelular spre spatiul extracelular (intravascular) pentru reglarea osmolaritatii plasmei → reglarea volumului plasmatic ; acest mecanism compensator are un aport mic in reglarea volumului plasmatic.

Mecanisme de compensare cardiovasculare in anemii cu instalare rapida.

Mecanisme de compensare renale in anemiile cu instalare rapida.
Trebuie mentionat ca mecanismele de compensare in anemiile cu instalare rapida se adreseaza, in primul rand, corectarii volumului plasmatic ; ulterior, hipoxia produce stimularea eritropoiezei. Pe de alta parte, in cadrul mecanismelor de compensare cardiovasculare, vasoconstrictia indusa de stimularea SNV simpatic depaseste cu mult vasodilatatia indusa de hipoxie.
Scaderea afinitatii hemoglobinei pentru oxigen
anemia → ↑ extractia de oxigen din sange de catre tesuturi → ↑ concentratiei de deoxihemoglobina din hematii → stimularea productiei de 2,3- difosfoglicerat (2,3-DPG)
2,3 - DPG deplaseaza curba de disociere a O2 de hemoglobina spre dreapta (↓ afinitatea hemoglobinei pentru O2), ceea ce permite o extragere mai usoara a O2 de catre tesuturi.
cresterea 2,3-DPG determina deplasarea curbei de
disociere a O2 de Hb spre dreapta cu eliberarea mai facila a O2 spre
tesutiuri

Fig.Curba de disociere a O2 in anemii.
prin vasoconstrictie selectiva se produce redistribuirea sangelui spre organele vitale (creier si cord). Organele care-si sacrifica respiratia aeroba sunt: pielea si rinichiul (care primeste in conditii normale o cantitate de sange mult mai mare decat necesitatile lui metabolice)
hipoxia tisulara determina activarea SNV simpatic si a SRAA → vasoconstrictie + cresterea reabsorbtiei de apa si Na+ → cresterea debitului cardiac
anemia trebuie sa fie severa (Hb < 7 g % ) pentru a apare cresterea debitului cardiac.
Cand toate mecanismele de compensare sunt depasite, prin severitatea anemiei, prin efort fizic intens sau prin prezenta unor afectiuni cronice concomitente, care compromit suplimentar perfuzia tesuturilor, apar manifestarile clinice caracteristice anemiei.
Fiziopatologia manifestarilor clinice
paloarea - prin redistribuirea volumului sanguin (suntarea tesutului cutanat si a mucoaselor) → paloarea pielii, a patului unghial si a mucoaselor;
tahicardia si palpitatiile - prin activarea SNV simpatic;
murmur sistolic - prin scaderea vascozitatii sanguine;
↑ debitului cardiac si hipertrofie ventriculara stanga, prin activarea SNV simpatic si a SRAA ; pacientii cu anemie severa pot prezenta simptome de insuficienta cardiaca congestiva.

Fig.. Palorea in anemii.
apar si manifestari clinice suplimentare fata de cele de mai sus:
hipotensiunea arteriala ortostatica (poate duce la sincopa) - prin scaderea reantoarecerii venoase la schimbarea posturii;
in anemiile hemolitice → icter - prin cresterea bilirubinei neconjugate in sange;
in anemiile aplastice - petesii si purpura - prin scaderea numarului si functionalitatii plachetelor;
in anemiile megaloblastice - pierderea sensibilitatii proprioceptive - prin afectarea tecii de mielina.

Fig.. Icter scleral
purpura petesii

Fig.. Petesii si purpura associate anemiilor aplastice.
Manifestarile clinice ale anemiilor posthemoragice, in functie de severitate
sunt importante deoarece parametrii de laborator pot fi N in faza acuta (Hb si Ht =N).
clasa I - pierdere sanguina < 15 % din totalul volumului sanguin - tahicardie usoara, TA =N;
clasa II - pierdere sanguina 15 - 30 % din totalul volumului sanguin - tahicardie medie, tahipnee, scadere usoara a TA, scaderea amplitudinii pulsului;
clasa III - pierdere sanguina 30- 40% din totalul volumului sanguin - tahicardie semnificativa, scadere medie a TA, scadere medie a amplitudinii pulsului;
clasa IV - pierdere sanguina > 40 % din totalul volumului sanguine, scadere semnificativa a TA si a amplitudinii pulsului.
clasa V - pierdere sanguina > 50 % din totalul volumului sanguin - TA nemasurabila, pierderea palparii pulsului ; necesita masuri de resuscitare, altfel se soldeaza cu deces.
Clasificarea etiopatogenetica a anemiilor
Anemii induse genetic/congenital
hemoglobinopatii (talasemii, siclemia, porfirii);
anomalii enzimatice intraeritrocitare;
anomalii membranale (abetalipoproteinemia);
anemia diseritripoietica congenitala;
anemia Fanconi.
Anemii prin deficit nutritional/metabolic
anemii prin deficit de fier;
anemii prin deficit de vit B12;
anemii prin deficit de acid folic;
anemii prin malnutritie.
Anemii posthemoragice;
Anemii aplastice;
Anemii asociate cu neoplazii sau afectiuni cronice (renale, hepatice, infectii cronice, colagenoze)
Anemii asociate cu infectii acute
Clasificarea anemiilor dupa perturbarea sintezei de hemoglobina
Anemii sideroblastice Porfirii Inflamatie cronica Neoplazii

ANEMII INDUSE GENETIC/CONGENITAL
Hemoglobinopatii:
talasemii
siclemia
porfirii
TALASEMII
Definitie
Sunt anemii induse genetic, caracterizate prin alterarea sintezei Hb, datorita scaderii ratei de productie a unor lanturi ale globinei (α, β, γ, δ ). Deoarece pentru sinteza Hb este necesara ansamblarea a 2 perechi de lanturi de globina diferite, lanturile sintetizate normal vor fi in exces fata de lanturile cu sinteza anormala, a caror rata de productie e scazuta. Excesul se acumuleaza intraeritrocitar, hematia devine instabila si este distrusa.
Dezechilibrul dintre ratele de productie a diferitelor lanturi de globina reprezinta marca tuturor tipurilor de talasemii.
Denumirea tipului de talasemie se face dupa tipul lantului cu sinteza deficitara sau absenta. Ex: talasemia beta + = productie scazuta a lanturilor beta ; talasemie beta 0 = productie absenta a lanturilor beta.
Fier HEM
Lant beta Lant alfa Lant beta Lant alfa Forma eliptica a lanturilor Hb hematie

Fig..Structura hemoglobinei
Caracteristici generale
Sinteza Hb necesita ansamblarea hemului cu globina. Globina este o structura tetrameica formata din 2 perechi diferite de lanturi. Toate structurile normale de Hb au in componenta lanturi alfa. In decursul dezvoltarii apar urmatoarele tipuri de Hb:
Hb embrionare (HbE)
Hb Portland (zeta2/gama2); zeta = lanturi alfa-like ;
Hb Gower I (zeta 2/epsilon2)
Hb Gower II (alfa2/epsilon2)
Hb fetale (HbF)
alfa2/gama2 - prezenta in cantitate de 65-95% din totalul de Hb la nou nascut
Hb adulte ( HbA)
Hb A1 - alfa2/beta2 = Hb adulta care se sintetizeaza incepand cu viata intrauterina
Hb A2 - alfa2/delta2.
Consecutiv scaderii productiei unor lanturi de globina se produce scaderea Hb in hematii. Apar astfel:
hipocromia;
microcitoza.
forma spoecifica a hematiilor in "semn de tras la tinta".

Fig.. Frotiu din sange periferic cu talasemie.
Excesul de lanturi normale se acumuleaza intraeritrocitar, precipita si reactioneaza cu membrana eritrocitara ; altereaza procesele biologice intraeritrocitare, inclusiv diviziunea celulara, provocand distrugerea hematiei (hemoliza).
In formele severe de talasemii (ex: beta talasemia majora - anemia Cooley), excesul semnificativ de lanturi alfa libere determina distructia precursorilor hematiilor din maduva osoasa → eritropoieza ineficienta.
Etiopatogenie
Talasemiile apar prin anomalii genetice la nivelul cromozomilor care controleaza sinteza lanturilor de globina:
la nivelul cromozomului 11 - se afla 5 gene care controleaza sinteza lanturilor beta si beta-like - beta, gama, delta.
la nivelul cromozomului 16 - se afla 3 gene care controleaza sinteza lanturilor alfa si alfa- like - alfa, zeta.
Se cunosc mai mult de 150 de mutatii la nivelul acestor cromozomi, care produc diferite tipuri de talasemii.
Ipoteza malarica
sugereaza ca mutatiile genetice au aparut de-a lungul timpului, la indivizii care au trebuit sa supravietuiasca in ariile geografice in care malaria este endemica. Ipoteza este argumentata de faptul ca anemiile precum talasemiile, siclemia si deficitul de glocozo-6-fosfat-dehidrogenaza sunt prezente aproape exclusiv in regiunile tropicale sau subtropicale.
mutatiile au aparut in scopul sintezei unei cantitati cat mai mari de HbF, care inhiba cresterea intraeritrocitara a parazitului malariei ;
Cele mai importante tipuri de talasemii sunt alfa si beta talasemiile.
Alfa-talasemia
este o afectiune rara
apare prin deletia uneia sau mai multor gene care controleaza sinteza lanturilor alfa ale globinei.
heterozigotii (talasemia alfa minora)- nu prezinta simptomatologie clinica si nici anomalii ale testelor de laborator
homozigotii (talasemia alfa majora) - in forma cea mai severa produce decesul intrauterin al fatului (hidrops fetal) ; apare datorita faptului ca fara sinteza lanturilor alfa nu se poate sintetiza hemoglobina F ; Hb gama 4, produsa intrauterin si Hb beta 4 (HbH) care apare postnatal, nu pot substitui functional HbF si HbA.
Beta-talasemia
apare prin deletia uneia sau mai multor gene care controleaza sinteza lanturilor beta ale globinei.
heterozigotii (talasemia beta minora) - sunt asimptomatici sau prezinta simptomele unei anemii usoare
homozigotii (talasemia beta majora - anemia Cooley) - prezinta simptome adeseori severe, prin urmatoarele mecanisme:
deficitul de HbA1 poate fi numai partial compensat de cresterea productiei de HbA2 si HbF;
lanturile libere alfa, in exces, formeaza incluzii intraeritrocitare insolubile si produc leziuni ale membranei hematiei;
incorporarea fierului in hematii este excesiva → sideroacrezia ; fierul se acumuleaza in exces si in organe → hemocromatoza ; acumularea fierului este agravata si de transfuziile terapeutice repetate;
excesul de fier in cord si ficat poate duce la insuficienta cardiaca si insuficienta hepatica.
desi rezistenta osmotica a hematiilor e crescuta, vulnerabilitatea lor mecanica este mare → hemoliza rapida in splina → splenomegalie si hipersplenism (raspuns hematopoietic excesiv la anemie).
HbF produsa in cantitati crescute are o afinitate crescuta pentru oxigen → eliberare dificila a O2 spre tesuturi → stimularea productiei de eritropoietina (dar cu o eritropoieza ineficienta datorata defectului genetic) → cresterea masei de tesut eritropoietic → hiperplazie medulara → expansiunea si deformarea oaselor.
deces inainte de pubertate prin insuficienta cardiaca sau/si hepatica.
Modificari ale oaselor craniului in talasemie


Hepatosplenomegalie in talasemie.
SICLEMIA
Definitie si caractere generale
Este o anemie indusa genetic, in care hematiile au un aspect caracteristic, in forma de secera ;
hematiiile cu forma patologica se aglutineaza ducand la aparitia fenomenelor ischemice, caracteristice siclemiei
este mai frecventa la afro-americani (1:500)
Etiopatogenie
Siclemia apare datorita sintezei unei Hb anormale (HbS) prin substitutia acidului glutamic cu valina in pozitia 6 a lantului beta al globinei.
Deoarece siclemia protejeaza impotriva malariei (HbS inhiba cresterea parazitului intraeritrocitar) si apare mai frecvent la populatia de rasa neagra, ipoteza malarica este valabila si in aceasta afectiune.
Heterozigotii
nu prezinta in mod obisnuit simptome clinice
simpotomatologia poate pare in conditii de hipoxie: exercitii fizice intense, urcarea la altitudine etc.
Homozigotii
dezvolta simptome numai dupa 4 luni (intrauterin si pana la 4 luni, prezenta HbF reduce tendinta la siclizare)
dupa varsta de 4 luni, HbS va inlocui 100 % toate formele de hemoglobina
HbS polimerizeaza, deformeaza hematiile → aglutinarea hematiilor → fenomene ischemice datorate ocluziilor microvasculare
datorita formei, hematiile au o rezistenta osmotica scazuta → hemoliza rapida in splina → splenomegalie si hipersplenism : maduva hematoformatoare este, de asemenea, hiperplazica.
ulterior, ischemiile splenice repetate determina aparitia fibrozei splinei si, mai tarziu, completa disparitie a splinei
infarctele pot apare si la nivelul creierului, rinichilor, plamanilor, ficatului, retinei, pielii, tesutului celular subcutanat sau oaselor → necroze aseptice
ocluziile microvasculare pot produce episoade durerose care pot dura ore sau zile.
Siclemia duce la deces prin:
hemoliza acuta masiva (criza hemolitica)
sechestrare splenica masiva a hematiilor datorita splenomegaliei (criza de sechestrare splenica)
stoparea eritropoiezei din maduva osoasa de infectii concomitente (criza aplastica).

Fig.. Frotiu din sange periferic. Siuclemie.
PORFIRII
Sunt afectiuni genetice determinate de tulburari ale sintezei protoporfirinei (necesara pentru sinteza HEM-ului).
Apar prin defecte enzimatice ale enzimelor implicate in sinteza protoporfirinei (are loc in maduva osoasa si in ficat)
Sunt caracterizate de cresterea productiei, acumularea excesiva si excretia produsilor intermediari necesari sintezei HEM-lui.

![]()

![]()
Sinteza a HEM-lui
HEM-ul inhiba delta-ALA-sintetaza prin feedback negativ ; daca sinteza HEM-ului e redusa (prin diverse defecte enzimatice), inhibitia delta-ALA-sintetazei nu mai are loc ; astfel, in ciuda defectului, se produc cantitati suficiente de HEM, dar cu cantitati aferente crescute de produsi intermediari → acumularea de porfirine (uroporfirine, coproporfirine si protoporfirine) in tesuturile eritropoietice si excretia lor prin urina si fecale.
Exista 2 grupuri de porfirii:
Porfirii eritropoietice
porfiria eritropoietica congenitala (deficit al UPG III sintetazei) - UP si CP sunt prezente in cantitati mari in hematii si urina ; este o anemie hemolitica severa
protoporfiria eritropoietica (deficit de ferokelataza) - protoporfirina este crescuta in hematii, dar e normala in urina ; poate apare anemie hemolitica intermitenta.
Porfirii hepatice
porfiria acuta intermitenta (deficit de PBG-deaminaza)
- cresc
coproporfiria ereditara (deficit de CPG-oxidaza) - creste CP III in urina si fecale ; nu determina anemie (porfirinele eritrocitare sunt normale)
porfiria variegata (deficit de protoporfirinogen - oxidaza) - creste protoporfirinogenul si CP in urina si fecale ; nu determina anemie (porfirinele eritrocitare sunt normale)
porfiria cutanea tarda (deficit de UPG-decarboxilaza) - singura care poate fi si dobandita (se poate asocial cu consumul de alcool, contraceptive sau expunerea la toxice industriale) ; cresc UP si CP in urina si fecale ; nu determina anemie (porfirinele eritrocitare sunt normale)
Din punct de vedere clinic, porfiriile se pot insoti de:
sindrom neurologic - patogeneza neclara
fotosenzitivitatea pielii - datorata acumularilor de porfirine in pile ; radiatiile UV produc oxidarea acestora → compusi care reactioneaza cu dermul si epiderma → pigmentari, leziuni veziculare si ulcerative.

Fig...Porfirie. Fotosensibilitatea pielii cu formare de vezicule/bule.
ANEMII PRIN ANOMALII ENZIMATICE INTRAERITROCITARE
Deficitul de fosfokinaza (PK) - enzima participanta la glicoliza
produce anomalii ale membranei hematiilor care devin rigide (osmotic fragile) → hemoliza intensa
determina o anemie hemolitica severa cu icter si splenomegalie
Deficitul de glucozo-6-fosfat-dehidrogenaza (G6P-DH) - enzima participanta la suntul hexozo-monofosfat
expune hematiile la actiunea substantelor oxidative → hemoliza prin acumularea intraeritrocitara de peroxide de hidrogen ; acumularea apare, in special, prin expunere la unele substante din fasolea fava (favism) sau din medicamente (sulfamide, acid nalidixic, unele antimalarice)
severitatea anemiei e variabila.
ANEMII PRIN DEFICIT NUTRITIONAL
ANEMII FERIPRIVE
Definitie, caractere generale
Anemiile feriprive sunt anemii datorate tulburarilor metabolismului fierului, produse prin dezechilibrul dintre aportul, absorbtia si eliminarea fierului.
Apar cand deficitul de fier este suficient de sever pentru a produce scaderea eritropoiezei si pentru a produce un deficit de sinteza a hemoglobinei.
Sunt cele mai frecvente forme de anemii.
Fe in depozite


Etiopatogenie
Aport scazut
prin malnutritie sau dieta inadecvata
prin aport scazut, comparativ cu necesitatile (sarcina, copilarie, adolescenta)
Tulburari de absorbtie a fierului
prin dieta bogata in substante care scad absorbtia fierului (fitati, oxalati, fosfati, carbonati, tanati)
prin hipo sau aclorhidrie (gastrite atrofice)- produc deficit de transformare a ionului feric in ion feros, scazand absorbtia acestuia
prin tulburari psihice cu ingestie de argila (pica) - argila leaga fierul in tractul gastrointestinal, scazandu-i absorbtia
prin rezectii intestinale intinse, gastrectomii
Pierderi crescute - apar in hemoragii:
acute - traumatisme, rupturi de varice esofagiene
cronice - menometroragii, hemoragii ale tractului gastrointestinal (ulcer gastric, ulcer duodenal, adenocarcinom gastric, adenocarcinom colo-rectal, hemoroizi, administrare de medicamente - AINS, preparate cortizonice), hemoptizie (bronsiectazie, cancer pulmonar), dieteze hemoragice (afectiuni ale plachetelor)
Depozitare crescuta a fierului
apare in hemosideroza pulmonara
Anemiile feriprive sunt microcitare, hipocrome si se trateaza uzual cu preparate de fier.
Anemiile feriprive netratate parcurg urmatoarele stadii:
depletia depozitelor de fier - se pierd depozitele de fier, fara compromiterea aprovizionarii cu fier pentru eritropoieza ; punctia medulara releva absenta fierului din histiocitele medulare ; feritina serica este scazuta
deficit de fier pentru eritropoieza - hematiile mature apar hipocrome si microcitare
anemie feripriva severa - microcitoza si hipocromia se accentueaza → anulocite
Fig. Anemie feripriva.

Fig.. Aspectul limbii in anemia feripriva

Fig.. Koilonichie in anemia feriopriva.
Anemia sideroblastica
Se caracterizeaza prin aparitia de sideroblasti (precursori de eritrocite cu depozite crescute de fier, care par sub forma de inel albastrul - coloratia cu albastru de Prusia) in maduva osoasa ;
Etiologie:
forme ereditare/congenitale - defecte enzimatice in sinteza HEM-ului
forme dobandite - consum de alcool, medicamente (cloramfenicol, izoniazida), neoplasme, inflamatii, chimioterapie.
Mitocondriile sunt incarcate cu fier in exces → eritropoieza ineficienta ; in sangele priferic se constaa microcitoza, hipocromie (prin defect de sinteza a HEM-ului) ; fierul seric e crescut; transferina e suprasaturata cu fier.
ANEMII MEGALOBLASTICE
Definitie
Sunt anemii care rezulta din dezechilibrul dintre aportul de cofactori necesari pentru sinteza ADN-ului si necesitatile pentru productia acestuia ; cei mai importanti cofactori pentru sinteza ADN-ului sunt vitamina B12 si acidul folic.
Caractere generale
primele celule afectate sunt cele cu turnover crescut, in special precursorii hematopoietici si celulele epiteliale ale tractului gastro-intestinal
datorita scaderii sintezei ADN-ului, diviziunea celulara este incetinita, dar citoplasma se dezvolta normal; nucleul ramane in celula, celula creste in dimensiuni → disproportie nucleu/citoplasma → aspectul caracteristic megaloblastilor
celulele megaloblastice sunt distruse in numar mare in maduva osoasa → eritropieza ineficienta.
ANEMII MEGALOBLASTICE PRIN DEFICIT DE VITAMINA B12 (CIANCOBALAMINA)
Vit. B12 intervine in metabolismul folatului, cofactor esential pentru sinteza ADN-ului, catalizand reactia de transformare a homocisteinei in metionina ; reactia este necesara pentru transformarea folatului din forma inactiva in forma active.
Absorbtia vitaminei B12.

Etiopatogenie
Deficit nutritional de vit.B12 - o alimentatie normala asigura un aport de 5-15 mg/zi (necesar = 2 mg/zi) ; rezervele formate dureaza 2-5 ani in lipsa aportului ; grupe de risc crescut: alcoolismul cronic, alimentatia vegetariana.
Tulburari de absorbtie a vit. B12
orice proces care suprima productia de acid clorhidric la nivelul stomacului (gastrite atrofice, cancere gastrice, gastrectomie, medicamente - alcalinizante ale secretiei gastrice)
productia inadecvata de factor intrinsec: distructia celulelor parietale gastrice prin mecanism autoimun (anticorpi anti-celula parietala gastrica = anemia pernicioasa); gastrectomia ; absenta congenitala a factorului intrinsec.
afectiuni ale intestinului - enterita regionala, neoplasme intestinale, rezectii intestinale intinse, celiachie (sprue non-tropical), sprue tropical, boala Whipple, sindromul Imerslung (deficit ereditar de absorbtie a vit. B12 + proteinurie), boala Crohn.
deficitul ereditar de transcobalamina II
sindomul Zollinger-Ellison - cresterea secretiei de acid clorhidric si gastrina determina tulburari de absorbtie a vit B12.
Fiziopatologia sindroamelor clinice
Deficitul de vit B12 produce manifestari hematologice, neurologice, psihiatrice, gastro-intestinale, cardiovasculare.
neurologice - metionina formata din homocisteina (reactie catalizata de vit. B12) este necesara pentru producerea colinei care intra in structura unor fosfolipide membranale ale neuronului ; de asemenea, este necesara pentru metilarea proteinei bazice a mielinei ; deficitul de B12 se soldeaza cu demielinizare, urmata de degenerescenta axonului si moartea neuronului ; sunt afectati neuronii periferici, cordoanele posterioare si laterale ale maduvei spinarii (fasciculul piramidal incrucisat) si emisferele cerebrale parestezii, ataxie, tulburari de coordonare.
hematologice - frotiul din sangele periferic releva: megaloblastoza, anizocitoza, poikilocitoza ; PMN au nucleul hipersegmentat - fenomen foarte caracteristic (un nucleu cu 6 lobi sau mai multi, ridica imediat suspiciunea de megaloblastoza); frotiul medular - hipercelularitate cu megaloblastoza ; are loc o eritropoieza ineficienta cu distructia premature a eritroblastilor in maduva osoasa cresterea bilirubinei neconjugate si a LDH in sangele periferic ; precursorii granulocitelor si megacariocitelor sunt de asemenea afectati leucopenie si trombocitopenie.
psihiatrice - tulburari de memorie, iritabilitate, depresie, rar psihoze
digestive - glosita, anorexie cu scadere in greutate, acompaniate uneori de diaree ; celulele epiteliale ale mucosei intestinalesunt afectate (deoarece sunt celule cu turnover crescut) tulburari de absorbtie intestinala.
cardiovasculare - deficitul de vit B12 produce hiperhomocisteinemie, care reprezinta un factor de risc crescut pentru ateroscleroza, cu cresterea frecventei infarctului miocardic si a AVC ischemic.
ANEMII MEGALOBLASTICE PRIN DEFICIT DE ACID FOLIC
Acidul folic joaca un rol important in sinteza ADN-ului prin interventia sa in sinteza metioninei si a bazelor purinice (timina si pirimidina) si in catabolismul histidinei. Lipsa catabolismului histidinei duce la acumularea unui produs de metabolism intermediar = acidul formimino-glutamic (FIGLU), a carui determinare sanguina constituie marker de diagnostic.
Etiopatogenie
1.Aport inadecvat
alimentatie necorespunzatoare (acidul folic se gaseste in varza, brocoli, fasole, spanac etc)
necesitati crescute fiziologice - gravide, copii, adolescenti
necesitati crescute consecutive unor afectiuni cu eritripoieza foarte activa (ex: anemii hemolitice)
2.Tulburari de absorbtie
sprue (tropical, non-tropical = celiachie)
medicamente care inhiba absorbtia (ex: contraceptive orale, sulfasalazina, trimetoprim etc)
3.Toxice care interfereaza cu metabolismul folatului
alcoolul
barbituricele
Fiziopatologia simptomelor clinice
in general, sunt aceleasi ca si la deficitul de vit. B12, dar nu apar manifestari neurologice !
ANEMII MEGALOBLASTICE DE CAUZA MEDICAMENTOASA
Dupa deficitul de vit B12 si acid folic, cea mai comuna cauza de producere a anemiilor megaloblastice este ingestia unor medicamente:
Inhibitori directi ai sintezei ADN-ului
chimioterapice - azatioprina, 6-mercaptopurina, 5-fluorouracil etc
antivirale - acyclovir, zidovudin etc
Antagonisti ai folatului - metotrexat, trimetoprim
Antagonisti ai cobalaminei - anestezii generale repetate cu oxid nitros
Alte medicamente (mecanism necunoscut) - Fenitoinul si Fenobarbitalul.

Fig.. Megaloblastoza.
ANEMII POSTHEMORAGICE
Etiologie
hemoragii acute - traumatisme, hemoragii alveolare dupa extractii dentare, hemoragii postpartum/postabortum, rupturi de anevrisme, tratamentul cu anticoagulante
hemoaragii cronice - hemoragii gastrointestinale, hemoragii prin afectiuni ale hemostazei.
Raspunsul fiziopatologic in hemoragiile acute
Faza hipovolemica: tahicardie, scaderea TA, vasocontrictie periferica cu paloare, oligoanurie ; socul hipovolemic apare cand exista o pieredere acuta > 15-20% din sangele circulant ; raspunsul hematologic in faza hipovolemica - imediat dupa hemoragie se produce o scadere proportionala a volumului sanguin circulant, a hematiilor, a hemoglobinei si a hematocritului ; in decurs de 3 ore posthemoragie se produce o crestere rapida a volumului sanguin circulant prin mecanism renal (oligurie) ; dupa 2-3 zile volumul plasmatic devine normal, hematiile, hemoglobina si hematocritul raman scazute.
Faza anemica: intre 3- 14 zile - anemie normocroma, normocitara, cu H, Hb, Ht scazute ; la 14 zile reticulocitele sunt normale; la 4-6 saptamani se normalizeaza nr. de H si Ht ; la 6-8 saptamani - se normalizeaza Hb.
Raspunsul fiziopatologic in hemoragiile cronice
- hemoragiile cronice nu modifica volumul sanguin circulant, dar determina anemii feriprive hipocrome, microcitare.
ANEMII AUTOIMUNE
Definitie
Anemiile autoimmune (AA) sunt anemii hemolitice in care anticorpii sunt indreptati impotriva unor antigene de pe membrana hematiilor.
Caractere generale
daca anticorpii sunt de tip IgG, hemoliza poate apare la orice temperatura ; se produc, in general, la anumite medicamente.
daca anticorpii sunt de tip IgM, hemoliza apare la temperaturi scazute (sindromul de aglutinare la rece) ; acest sindrom poate avea 2 tipuri de manifestari : poate fi tranzitoriu, in cazul in care insoteste mononucleoza infectioasa sau infectiile cu Mycoplasma pneumoniae. ; poate apare sub forma hemoglobinuriei paroxistice la rece, cand hemoliza are loc invariabil, prin expunere la temperature scazute.
anemiile hemolitice alloimune - anticorpii de tip IgG sunt sintetizati impotriva unor antigene de pe membrana eritrocitara (antigene non-self) - anemii prin incompatibilitate ABO sau Rh (transfuzii sau sarcina cu incompatibilitate Rh - mama Rh -, tata Rh +).
caracterele anemiilor autoimune se suprapun peste caracterele anemiilor hemolitice.

Fig.. Test Coombs in anemii autoimmune.

Fig.. Hemaglutinare in anemii hemolitice.
ANEMII HEMOLITICE
includ anemiile autoimune si alte tipuri de anemii
Clasificare etiopatogenetica
Intracorpusculare
prin anomalii de membrana - abetalipoproteinemia (acantocitoza), sferocitoza ereditara, eliptocitoza ereditara etc
prin anomalii intracelulare - talasemii, hemoglobinopatii, defecte enzimatice intraeritrocitare
Extracorpusculare
prin factori extrinseci - traume mecanice, splenomegalia, paraziti (malaria)
prin anticorpi - anemii autoimune
Caracteristici
hemoliza poate avea loc intravascular (in circuitul sanguin) sau extravascular (in sistemul reticuloendotelial)
eritropoieza este normala, dar ritmul sau nu este corespunzator ritmului accelerat de distructie a hematiilor
anemiile hemolitice se insotesc de reticulocitoza, fiind puternic regenerative
hemoliza determina cresterea concentratiei serice a bilirubinei indirecte si a urobilinogenului in ser si urina
se insotesc de scaderea haptoglobinei serice (se leaga de hemoglobina rezultata din hemoliza).
ANEMII APLASTICE
Definitie
Sunt afectiuni caracterizate prin incapacitatea maduvei osoase de a forma precursori eritroizi ; maduva osoasa este hipo sau acelulara, de aceea se produce pancitopenie (anemie, leucopenie, trombocitopenie); rar, aplazia este selectiva, numai pe linia eritrocitara.
Etiologie
Anemia aplastica eritrocitara pura
- ereditara - sindomul Diamond-Blackfan
- dobandite - idiopatice, in cadrul limfoamelor, infectiilor, timomului.
Anemii aplastice insotite de trombocitopenie si leucopenie
- ereditara - anemia Fanconi - autosomal recesiva, asociata cu anomalii cardiace, renale, anomalii ale scheletului si ale pielii
- dobandite:
- idiopatice
- prin agenti fizico-chimici - radiatii ionizante, radioterapia, chimioterapia, insecticide, cloramfenicol
- imune - prin limfocite T citotoxice care produc IFN gama si TNF alfa ce induc apoptoza celulelor stem pluripotente
- prin infectii - pot pare ca si complicatii deosebit de severe ale mononuclozei infectioase, hepatitelor, SIDA
- prin infiltrate medulare (anemii mileoftizice) - in tumori, limfoame etc.
Fiziopatologia manifestarilor clinice
scaderea productiei eritrocitelor → sindrom anemic
scaderea productiei trombocitilor → tulburari ale hemostazei primare (purpura, petesii, hemoragii usoare)
scaderea productiei de leucocite → scaderea apararii impotriva infectiilor.
ANEMII CARE INSOTESC BOLI CRONICE
Definitie
Sunt anemii care insotesc anumite categorii de afectiuni cronice: infectii cronice, boli inflamatorii cronice non-infectioase, neoplazii, insuficienta renala cronica.
Caractere generale
anemia apare dupa 1-2 luni de la debutul bolii cronice, poate fi asimptomatica sau cu manifestari clinice variabile.
gradul anemiei se coreleaza cu severitatea bolii cronice pe care o insoteste.
Etiopatogenie
Infectii si boli inflamatorii cronice non-infectioase (colagenoze)
hematiile sunt distruse prin hemoliza indusa de endotoxinele bacteriene si de citokinele proinflamatoare
exista o eritropoieza compensatoare dar ineficienta ; ineficienta se datoreaza inhibitorilor eritropoiezei eliberati din macrofagele si neutrofilele activate in cursul procesului inflamator.
mediatorii endogeni leucocitari favorizeaza depunerea fierului plasmatic in ficat si splina → scaderea concentratiei fierului plasmatic si scaderea cantitatii de fier transportata spre maduva osoasa
lactoferina (crescuta in neutrofile) competitioneaza cu transferina pentru legarea fierului : in conditii normale, transferina transporta fierul spre maduva osoasa ; fierul legat de lactoferina este indepartat de sistemul reticuloendotelial → scaderea concentratiei fierului plasmatic si a cantitatii transportate spre maduva osoasa.
Neoplazii
Hematiile sunt distruse prin hemoliza indusa de:
hemolipine = agenti hemolitici eliberati din hematii
intrarea hematiilor in sistemul circulator al tumorii (neovase cu structura si functie diferita de a vaselor normale → hemoliza)
mecanism imun - tumorile stimuleaza productia de anticorpi anti-antigene de pe membrane eritrocitara.
distructia hematiilor de catre macrofagele activate de factori eliberati de tumora.
Insuficienta renala cronica
Anemia apare prin:
scaderea duratei de viata a hematiilor, datorita actiunii toxinelor uremice
scaderea aportului nutritional asociat uremiei
scaderea eritropoiezei datorita scaderii productiei de eritropoietina
pierderea de hematii prin hemoragii (hemoragiile apar prin disfunctie plachetara indusa de uremie).
ANEMII CARE INSOTESC INFECTII ACUTE
Sunt caracteristice infectiilor virale acute si parazitare (malaria).
Mecanismele de producere sunt reprezentate de:
scaderea aportului de factori nutritionali
activarea sistemului monocite/macrophage, cu eliberarea de mediatori proinflamatori, care pot induce hemoliza
invadarea maduvei osoase de catre virusuri, fenomen care impiedica o eritropoieza corespunzatoare.

Fig.. Parazit intraeritrocitar in malaria.
FIZIOPATOLOGIA POLICITEMIILOR
Definitie - afectiuni caracterizate prin cresterea numarului de hemoatii in sangele periferic.
Clasificare etiopatogenetica
Policitemii relative
apar cand se produce scaderea volumului plasmatic (prin pierderi acute de plasma)
eritropoieza este normala
Policitemii absolute
Primare
Policitemia Vera
este o afectiune neoplazica sanguina caracterizata prin cresterea productiei tuturor liniilor celulare mieloide (cu cresterea hematiilor, leucocitelor si trombocitilor in sangele periferic);
determina aparitia sindromului de hipervascozitate sanguina, cu crestere riscului la tromboze si hemoragii: tromboze - prin activarea procesului de hemostaza, hemoragii - prin distensia peretelui vascular, cu cresterea riscului de rupturi vasculare.
eritropoietina este normala sau scazuta → stimularea exagerata a eritropoiezei se produce prin alt mecanism.
Secundare
hipoxice (hipoxia stimuleaza eritropoieza) - in boli cardiace, pulmonare, la altitudini inalte (policitemie fiziologica, de adaptare)
tumori secretante de eritropoietina - carcinoame renale, hepatoame, hemangioblastom cerebelos.
FIZIOPATOLOGIA LEUCEMIILOR
Definitie - reprezinta neoplazii sanguine, cu cresterea numarului de leucocite sau a precursorilor lor.
Caractere generale
anomaliile cromozomiale de la nivelul leucocitelor, care controleaza diviziunea celulara, determina multiplicarea necontrolata a acestora;
celulele leucemice invadeaza maduva osoasa si alte organe (ficat, splina, noduli limfatici, creier etc)
Clasificare
Leucemii acute - leucemia limfoida acuta, leucemia mieloida acuta
Leucemii cronice - leucemia limfoida acuta, leucemia mieloida cronica
leucemiile limfoide (limfoblastice) - proliferare necontrolata a limfocitelor sau a precursorilor lor
leucemiile mieloide (mieloblastice) - proliferare necontrolata a precursorilor de PMN, bazofile, eozinofile, monocite.
Etiologie
necunoscuta
sunt cunoscuti anumiti factori de risc:
expunerea la radiatii sau chimioterapie
boli ereditare: boala Down, sindomul Fanconi
virusuri: HTLV - 1 (human T-cell lymphotrophic virus tip 1) - similar cu HIV - produce o forma rara de leucemie, leukemia cu celule T
virusul Ebstein-Barr - a fost asociat cu anumite forme de leucemie limfoida.
Patogeneza
Leucemia limfoida acuta
poate apare la orice varsta, dar e mai frecventa la copii intre 2-5 ani
se produce acumularea de celule leucemice imature in maduva osoasa → distructie medulara;
celulele leucemice ajung in torentul sanguin si, de aici, in creier (iritatia meningelui - meningita), in maduva spinarii (paraplegie), in ficat (insuficienta hepatica), in rinichi (insuficienta renala)
Leucemia mieloida acuta
poate apare la orice varsta, dar e mai frecventa la adulti
precursorii de PMN, Ba, Eo au Mo se acumuleaza in maduva osoasa si alte organe, determinand aceleasi manifestari clinice ca si ale leucemiei limfoide acute.
pot forma mase tumorale mici sub piele, gingii, orbite (cloroame)
Leucemia limfoida cronica
mai frecventa la barbatii peste 60 de ani
limfocitele mature cresc necontrolat, initial in sangele periferic si nodulii limfatici; apoi populeaza ficatul si splina (hepatosplenomegalie), iar, in cele din urma, invadeaza si maduva osoasa
in 95 % din cazuri prolifereaza limfocitele B, iar in 5% limfocitele T
sindromul Sezary = leucemie limfoida cu limfocite T care debuteaza ca si un cancer cutanat - micoza fungoida - apoi, din acest loc, se raspandeste si in alte organe.
Leucemia mieloida cronica
mai frecventa la adulti intre 40 - 60 de ani, egal la ambele sexe.
celulele leucemice sunt produse in maduva osoasa ; spre deosebire de forma acuta, unde prolifereaza celulele imature, aici creste numarul celulelor mature (PMN, Ba, Eo, Mo)
treptat, inlocuiesc tesutul medular, se raspandesc in sangele periferic si apoi in alte organe
in cursul evolutiei se produc crizele blastice care sunt semn de agravare a bolii ; se insotesc de febra, splenomegalie, scadere in greutate.

Fig.. Luucemie acuta limfoblastica.
FIZIOPATOLOGIA LIMFOAMELOR MALIGNE
Definitie - transformare neoplazica a celulelor sistemului limfatic (neoplazii solide ale sistemului imunitar)
Exista 2 categorii de limfoame maligne:
limfoame maligne Hodgkiniene
limfoame maligne non-Hodgkiniene
Caracteristici
|
Caracteristici |
Limfoame non-Hodgkiniene |
Limfoame Hodgkiniene |
|
1. Celule neoplazice caracteristice |
- limfocite B-90% -limfocite T-10% |
-celule Reed-Sternberg (prezinta caractere atat de LfB cat si de LfT) |
|
2.Localizare - forme localizate - proliferare in ganglionii limfatici - proliferare extranodala - proliferare mediastinala - proliferare abdominala - proliferare in maduva osoasa |
-rar -limfadenopatie persistenta -frecvent -rar -frecvent -frecvent |
-frecvent -limfadenopatie persistenta -rar -frecvent -rar -rar |
|
3.Translocatii cromozomiale |
-prezente |
-nedescrise |
|
4. Curabilitate |
< 25% |
> 75% |
|
Politica de confidentialitate | Termeni si conditii de utilizare |

Vizualizari: 11341
Importanta: ![]()
Termeni si conditii de utilizare | Contact
© SCRIGROUP 2025 . All rights reserved